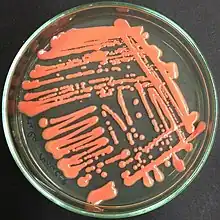

| Microbotryomycetes | |
|---|---|
![]() | |
| Rhodotorula mucilaginosa, yeast colony in culture | |
| Scientific classification | |
| Domain: | Eukaryota |
| Kingdom: | Fungi |
| Division: | Basidiomycota |
| Subdivision: | Pucciniomycotina |
| Class: | Microbotryomycetes R. Bauer, Begerow, J.P.Samp., M.Weiss & Oberw. (2006)[1] |
| Orders | |
| |
The Microbotryomycetes are a class of fungi in the subdivision Pucciniomycotina of the Basidiomycota. The class currently contains eight orders, plus three additional, unassigned families (Chrysozymaceae, Colacogloeaceae, and Mycogloiocolacaceae), plus seven additional, unassigned genera (Oberwinklerozyma, Pseudohyphozyma, Reniforma, Spencerozyma, Trigonosporomyces, Vonarxula, and Yunzhangia).[2][3] Many species are known only from their yeast states. Species with hyphal states typically produce auricularioid (laterally septate) basidia and are often parasitic on other fungi or plants. Several species in the genera Rhodotorula and Sporobolomyces are opportunistic human pathogens.
References
- ↑ Bauer R, Begerow D, Sampaio JP, Weiss M, Oberwinkler F (2006). "The simple-septate basidiomycetes: a synopsis". Mycological Progress. 5 (1): 41–66. doi:10.1007/s11557-006-0502-0. S2CID 26613287.
- ↑ Wang Q, Yurkov AM, Göker M, Lumbsch HT, Leavitt SD, Groenewald M, Theelen B, Liu X, Boekhout T, Bai F (2016). "Phylogenetic classification of yeasts and related taxa within Pucciniomycotina". Studies in Mycology. 81: 149–189. doi:10.1016/j.simyco.2015.12.002. PMC 4777780. PMID 26951631.
- ↑ Schoutteten N, Yurkov A, Leroux O, Haelewaters D, Van Der Straeten D, Miettinen O, Verbeken A (2023). "Diversity of colacosome-interacting mycoparasites expands the understanding of the evolution and ecology of Microbotryomycetes". Studies in Mycology. 106: 41–94. doi:10.3114/sim.2022.106.02.
This article is issued from Wikipedia. The text is licensed under Creative Commons - Attribution - Sharealike. Additional terms may apply for the media files.